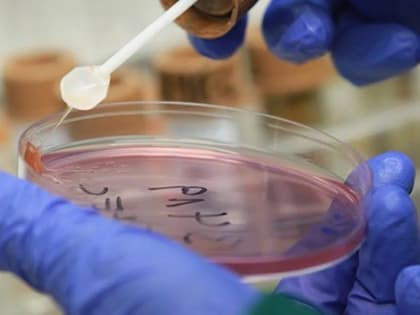
Заболеваемость ОКИ в Ростове превышает многолетние уровни – выделены штаммы холеры

Здоровье

В Ростовской области готовятся к вспышке ОРВИ и гриппа
В Ростовской области выросли показатели по заболеваемости гриппом и ОРВИ.

15 сентября Роспотребнадзор отмечает 101-ю годовщину создания санитарной службы России
Деятельность санитарно-эпидемиологической службы можно охарактеризовать такими словами, как профилактика, защита, мониторинг, контроль.

В Ростовской области на 8,7% превышен эпидемический порог по ОРВИ
В Ростовской области начался сезон ОРВИ.

В сторону Ростова: поезд здоровья «Вместе против диабета» отправился в путь по стране
Ростовская область, 14 сентября 2023. DON24.RU.

О необходимости вакцинации против гриппа
Близится осень, а значит, сезонный подъем заболеваемости гриппом.
Заболеваемость ОКИ в Ростове превышает многолетние уровни – выделены штаммы холеры
В последнее время резко пошла вверх заболеваемость острыми кишечными инфекциями (ОКИ).

Заболеваемость ОРВИ в Волгодонске выросла на 47%, эпидпорог в Ростовской области превышен
Как сообщает городская администрация, случаев коронавирусной инфекции на прошлой неделе зафиксировано не было.

Опухоль размером с большой арбуз удалили хирурги из живота пациента в Сочи
Врачам удалось полностью извлечь 6-кг опухоль.

Когда в Волгодонске продолжится вакцинация против гриппа
Как сообщает городская администрация, с начала вакцинации против гриппа в Ростовской области – а началась она 28 августа – в Волгодонск по линии Минздрава поступили 4070 доз вакцины.

Пуд соли — для здоровья
Подопечные социально-реабилитационного отделения,